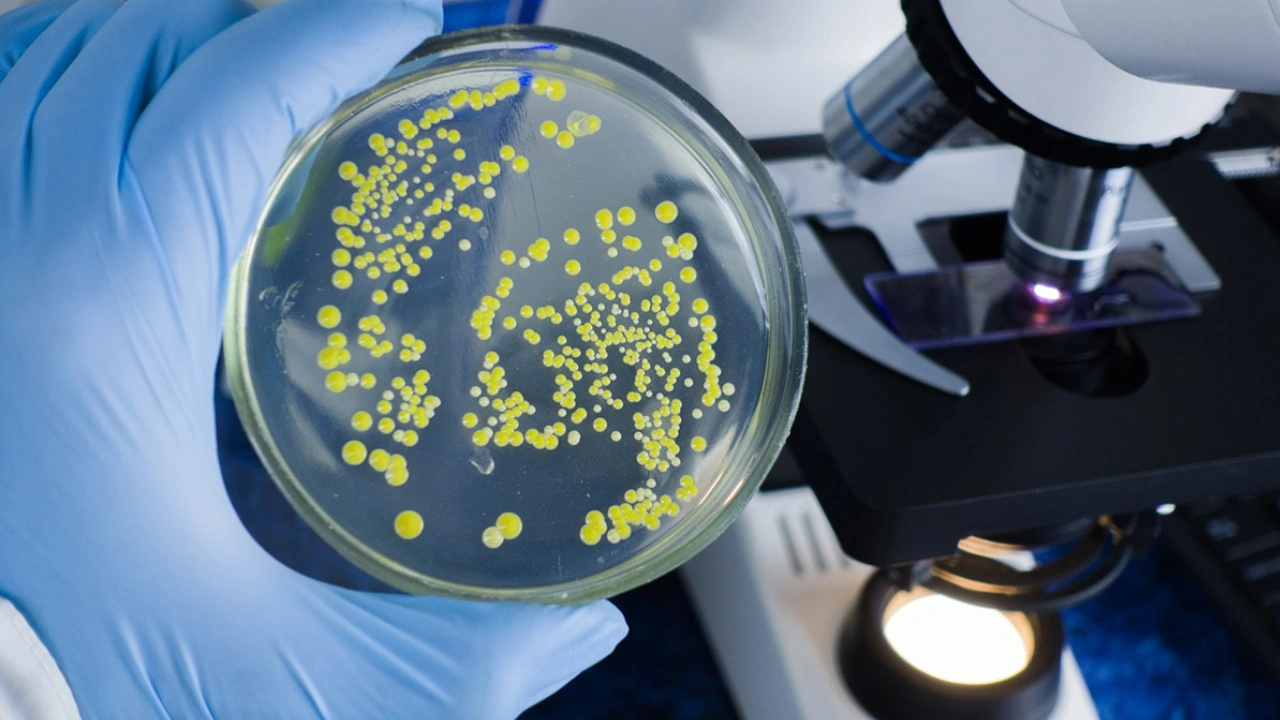

Ukrayna’daki savaş, sadece insani ve siyasi krizlere yol açmakla kalmıyor, aynı zamanda sağlık sektörü üzerinde de büyük bir tehdit oluşturuyor. Bilim insanları, savaş bölgesinde yayılan ve çoğu antibiyotiğe direnç gösteren “aşırı patojenik” süper bakteri konusunda kritik uyarılarda bulunuyor. Bu bakterilerin artışı, tıbbi tedavi olanaklarını kökten tehdit ediyor.
Araştırma Bulguları İç Karartıyor

Bilim insanları, Ukrayna’daki savaşta yaralanan 150 kişiden aldıkları numuneleri analiz etti. Sonuçlar, sağlık sistemini derinden sarsacak kadar korkutucu. Test edilen bakterilerin %6’sı, mevcut tüm antibiyotiklere tamamen dirençli çıktı.
Özellikle dikkat çeken süper bakteri türü olan Klebsiella pneumoniae, zatürreden idrar yolu enfeksiyonlarına kadar çeşitli hastalıklara neden olabiliyor. Bu bakteri türü, antibiyotiğe dirençli enfeksiyonlardan kaynaklanan ölümlerin %20’sine yakınından sorumlu.
Araştırmada, Klebsiella pneumoniae bakterisinin genom dizilimi incelendi ve dirençle ilişkili genlerın taşındığı tespit edildi. Dr. Kristian Riesbeck, bakterilerin “dışarıdan tedaviye direnç gösteren ve aynı zamanda son derece sıldırgan” yapıda süper bakteri olduğunu belirtti.
Süper Bakteri Neden Bu Kadar Tehlikeli?
Klebsiella pneumoniae bakterisi, hastalık yapıcı özelliklerini daha da güçlendiren genetik unsurlarıyla dikkat çekiyor. Dr. Riesbeck, bu bakterilerin özellikle çok miktarda mukus üretmesinin, tedaviyi daha da zorlaştırdığını söyledi. Mukus tabakası, antibiyotiklerin etkili olmasını neredeyse imkansız hale getiriyor.
Bilim insanlarının fareler ve böcek larvaları üzerinde yaptığı deneylerde, Ukrayna’dan alınan bakterilerin enfeksiyonu yayma kapasitesinin son derece yüksek olduğu kanıtlandı. Araştırmacılar, antibiyotiklere en dirençli bakterilerin, hem farelerde hem de böcek larvalarında en uzun süre hayatta kalan türler olduğunu vurguladı.
Genetik Yapıları İnceleniyor

İncelenen tam dirençli Klebsiella pneumoniae bakterilerinin hepsi, şişkin genetik yapılarıyla fark yaratıyor. Dr. Riesbeck, “Bu bakteriler, direnci ve sıldırganlığı bir araya getiren genlere sahip. Bu durum, gelecekte tedavi için karşımıza çok büyük bir engel çıkabilir anlamına geliyor” dedi.
Araştırmacılar, Ukrayna’da yaralı hastalar arasında yayılan bu bakterilerin, izolasyon ve doğru tedavi uygulanmadığı takdirde kontrol altına alınmasının imkansız hale geleceğine dikkat çekiyor.
Ne Yapılabilir?
Bilim insanları, öncelikli olarak bu tür bakterilerle enfekte olmuş hastaların izole edilmesi gerektiğini belirtiyor. Aksi takdirde, savaşın etkisiyle zaten zayıflamış olan Ukrayna sağlık sistemi üzerindeki baskı daha da artacak.
Araştırma ekibi, “Ukrayna’daki savaşın yol açtığı bu büyük sorun, sadece yerel değil küresel bir tehlike oluşturuyor. Direnci kıran yeni tedavi yöntemlerinin hızlıca geliştirilmesi şart” diyerek uyarıda bulundu.